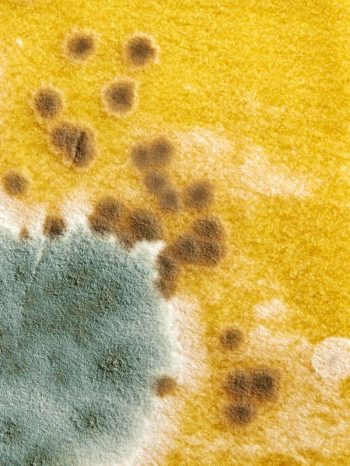
Exterior Cleaning Unlimited Mold Types

Effects Of Mold On A Home Exterior
If left untreated, it can spread and stain the surface or even weaken the materials used to protect the exterior of your home. While molds are organic material, completely eliminating them is impossible – but the key is to control it’s growth. Growth control entails knowing the type of mold as well as the surface it is growing on. Sometimes treating just the surface can eliminate spore growth. There are over 300,000 different types of mold. We will go over the most common ones.
Arthrinium – Derived from flowering plants which have been mixed with dirt/soil. Once formed, can be spread to exterior surfaces such as building walls, patio/porch furniture and cement surfaces by bugs, insects or reptile types.
Chrysosporium – Mainly from soil, plant material, dung, and birds. It lives on remains of hairs and feathers in soil. According to drfungus.com this mold may cause skin infections in humans.
Curvularia – Common inhabitant of dead plant material such as overly moist grass along house or pavement walls. When viewed under a microscope, this resembles a plant itself.
Dreschlera – This mold is also considered a plant pathogen causing leaf spot, crown rot, and root rot of various turf grass species. This specific mold is a little different as the more it rains or gets wet, the more destructive it is.
Emericella – Found in soil and decomposing wood. This type of mold actually morphs and forms a more common indoor mold type found inside most homes. Moist wood is it’s favorite habitat, using a more organic housing to continue its path of growth and change.
Epiccocum – Is a major allergen and irritant. Epicoccum is regarded as a secondary colonizer. Its presence indicates that other potentially more dangerous fungi are present. These fungi will stain, is considered to be florescent in color, and lives in everything outside.
With all of this knowledge about common mold species outside, we must be cognitive of organic items such as tree leaves, grass, bushes, branches, etc. being left on and around the surface areas of your home. Keep the exterior walls of your home and patio/porch furniture clean on a regular basis to control mold growth. Contact Exterior Cleaning Unlimited and get set up on a regular cleaning schedule to make sure mold growth is kept under control, leaving your house and family safe from unseen, airborne toxins.